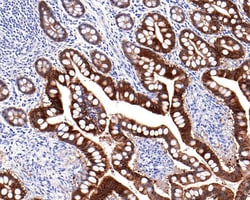
Invitrogen Villin Recombinant Rabbit Monoclonal Antibody (C4) 100 &mu;L;

missing translation for 'onlineSavingsMsg'
Learn More
Learn More
Invitrogen™ Villin Recombinant Rabbit Monoclonal Antibody (C4)
Rabbit Recombinant Monoclonal Antibody
Brand: Invitrogen™ MA544680
This item is not returnable.
View return policy
Description
Villin Recombinant Monoclonal Antibody for Western Blot, IHC (P)
Villin is part of cytoskeleton associated with the microvillar actin core bundle of gastrointestinal and renal brush border. It can interact with actin in a Ca2+ and phosphoinositide-regulated manner. Villin is a very specific marker for adenocarcinomas of the gastrointestinal tract and the pancreas. It is also expressed in some Merkel cell tumor and adenocarcinoma of the lung, prostate, ovarian and kidney.
Specifications
| Villin | |
| Recombinant Monoclonal | |
| 1 mg/mL | |
| PBS with 0.05% BSA, 40% glycerol and 0.05% sodium azide; pH 7.4 | |
| P09327 | |
| VIL1 | |
| Recombinant protein within human Villin1 aa 600-827. | |
| 100 μL | |
| Primary | |
| Human | |
| Antibody | |
| IgG |
| Immunohistochemistry (Paraffin), Western Blot | |
| C4 | |
| Unconjugated | |
| VIL1 | |
| D2S1471; OTTHUMP00000207159; Vil; Vil1; villin 1; villin-1 | |
| Rabbit | |
| Protein A | |
| RUO | |
| 7429 | |
| Store at 4°C short term. For long term storage, store at -20°C, avoiding freeze/thaw cycles. | |
| Liquid |
Product Content Correction
Your input is important to us. Please complete this form to provide feedback related to the content on this product.
Product Title
Spot an opportunity for improvement?Share a Content Correction